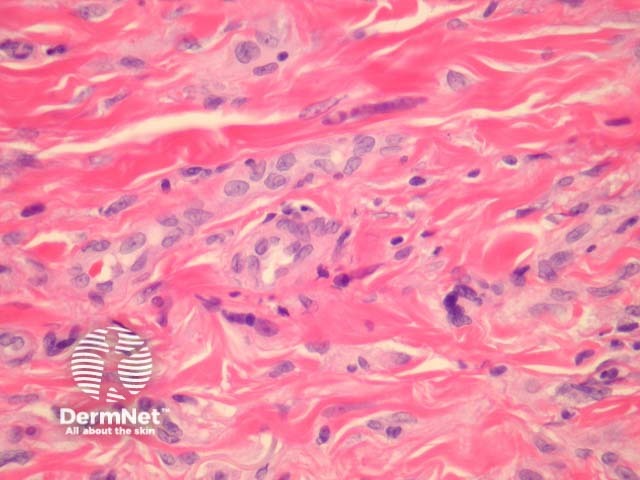
Figure 4

Main menu
Common skin conditions
NEWS
Join DermNet PRO
Read more
Quick links
Lesions (benign) Diagnosis and testing
Author: Assoc Prof Patrick Emanuel, Dermatopathologist, Auckland, New Zealand, 2013.
Multinucleate cell angiohistiocytoma presents clinically as asymptomatic red-to-brown tumors, with a tendency to confluence.
In multinucleate cell angiohistiocytoma, sections show abundant small dilated blood vessels and fibroplasia, principally in the mid-dermis (figure 1, 2). Higher power shows scattered bizarre cells (figures 3, 4) showing a pale basophilic cytoplasm and several nuclei arranged at the cell periphery (figure 3, arrow). A perivascular inflammatory infiltrate may also be seen.

Figure 1

Figure 2

Figure 3
Figure 4
The multinucleate cells stain with vimentin and factor XIIIa. S100, CD34, and CD31 are negative.
Dermatofibroma – Some authors consider multinucleate cell angiohistiocytoma to be a variant of dermatofibroma. Dermatofibromas typically do not display the same degree of vascularity or the characteristic giant cells.